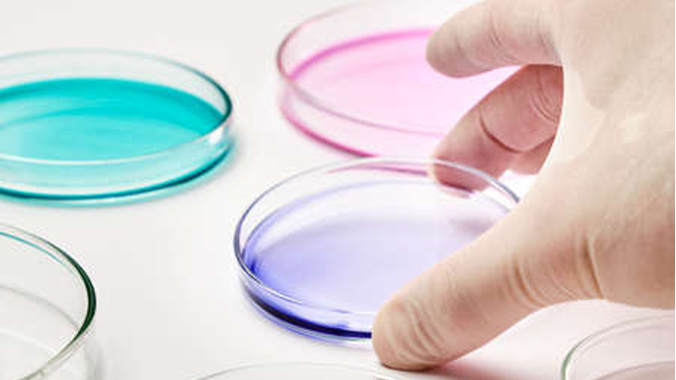

肉鸭传染性浆膜炎的病因分析及防控
心包炎、肝周炎是肉鸭养殖过程中常见的临床表现,主要病原以鸭疫里默氏杆菌为主,该病原主要侵害1-7周龄,导致纤维素性心包炎、肝周炎、气囊炎和脑膜炎等,死亡率为30%-75%。目前临 石脾等为主。我公司检测中心针对死淘率较高的肉鸭群采集大量病料进行病毒检测和细菌分离,分析发病原因,检测如下:
心包炎、肝周炎是肉鸭养殖过程中常见的临床表现,主要病原以鸭疫里默氏杆菌为主,该病原主要侵害1-7周龄,导致纤维素性心包炎、肝周炎、气囊炎和脑膜炎等,死亡率为30%-75%。目前临床剖检主要以心包积液、心内外膜出血、心包炎、肝周炎、大理石脾等为主。我公司检测中心针对死淘率较高的肉鸭群采集大量病料进行病毒检测和细菌分离,分析发病原因,检测如下:



1.病毒检测
选取病鸭的肝脏、脾脏、肺脏、气管、肾脏等器官,经过研磨、核酸提取之后,针对副黏病毒、星状病毒、腺病毒、黄病毒、H9、呼肠孤病毒进行PCR反应后,将产物进行凝胶电泳成像,如下图:

上图中:M:200bp DNA Ladder;1:副黏病毒;2:星状病毒; 3:腺病毒;4:黄病毒;5:H9;6:呼肠孤病毒;7:阴性对照
病毒PCR结果显示以上病毒检测均为阴性。
2.细菌分离鉴定
2.1细菌的初步分离
从鸭头中无菌挑取少量组织在TSA培养基上进行细菌的初步分离,18-24小时后,选取疑似菌落在TSA培养基和麦康凯分别进行纯化二次培养,待菌落进一步鉴定。

2.2浆膜炎血清型的鉴定
2.2.1 抗原处理
将传代纯化后的分离株进行二次纯培养, 18-24小时后取出于超净工作台内用高压灭菌PBS进行洗平板制成一定浓度的凝集抗原;将不同鸭疫里默氏杆菌阳性血清各取25 ul滴于已划好方格的玻片上,取凝集抗原25 ul进行玻片凝集反应,2min内观察结果。
2.2.2 结果判定
血清与玻片凝集抗原混匀后出现片状或颗粒状凝集即为阳性;未出现凝集者为阴性。

通过以上大量的病料数据分析,引起目前肉鸭大面积伤亡的病因并非病毒,而是细菌性疾病为主,伴随着细菌耐药性的增加,增加了临床治疗的难度。
3.与新希望六和的合作
随着肉鸭养殖的规模化发展和养殖量的快速上升,疾病的控制难度加大,肉鸭在近两年出现死淘率较高的案例逐渐增多,药物的效果不明显,给肉鸭养殖集团带来了较大损失。2018年新希望六和集团与我公司研发中心战略合作,对全国区域鸭疫里默氏杆菌进行了分离鉴定,对各个分公司血清型的分布有深入了解,经过科学的流调分析1、2、6、7型是目前我国大多数地区主要流行的血清型。由于各个区域流行血清型不同,采取了区域配型定制化服务,生产效益大大提高。
免疫程序
|
日龄 |
产品 |
|
1-3 |
鸭肝、大舌抗体 |
|
7 |
禽流感+浆大康 |
经过集团养殖场多批次的使用后,生产多个指标得到了极大提升,使用前后生产数据对比如下:
|
成活率 |
料肉比 |
均重 |
欧指 |
|
|
使用前 |
86% |
2.3 |
2.9 |
260 |
|
使用后 |
98% |
1.8 |
3.2 |
458 |

